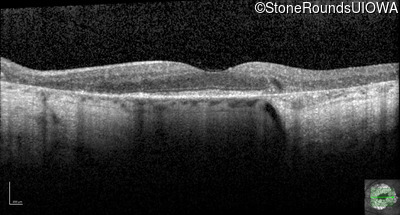

Case
SR2294
Student Mode
MIDD (IID1a)
Female
Female
Hidden
SR2294
Student Mode
MIDD (IID1a)
Female
Female
History
This 59 year old woman first experienced defects in her mid peripheral field in the past year. Her hearing worsened in her 30's and she started wearing hearing aids at age 40. She was diagnosed with diabetes at age 39 and began using insulin at age 42.